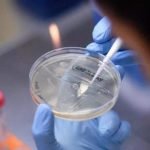
Covid-19: Salud reporta 44 muertes y 333 nuevos casos

Redacción Central
Paraguay registra el menor número de muertos por covid-19 en varios meses
En su informe de este domingo, el Ministerio Salud Pública indica que en las últimas 24 horas se procesaron 3.142 muestras, de las cuales...
Más de 300 kilos de cocaína incautada en San Cosme y Damián tenían a...
Los antidrogas de la SENAD intervinieron luego de que la droga haya sido descargada desde una aeronave.Un vehículo y el alijo de droga incautados....
Exitoso Angirü Encar Fest!!!
El evento gastronómico denominado Angirü Encar Fest se desarrolló en el Paseo Gastronómico y en la Réplica del Ferrocarril de la ciudad de Encarnación.Los...
Covid-19: Salud reporta 44 muertes y 333 nuevos casos
De acuerdo con el reporte del Ministerio de Salud Pública, procesaron 3.426 muestras de las cuales 333 dieron positivo por Covid-19. Además, registraron 44 nuevos decesos...
Primera jornada de vacunación con segunda dosis de Pfizer llega al 72%
El director del PAI, Héctor Castro, brindó los datos sobre el inicio de la aplicación de segundas dosis de la Pfizer e instó a...
Municipalidad de Encarnación efectuará la segunda entrega del almuerzo escolar
Las distribuciones inician este miércoles 04 de agosto y los centros educativos favorecidos serán: Escuela Bas. N° 1540 "Acosta Ñu, Escuela Bas. N° 818...
Accidentes en Itapúa dejaron un fallecido y dos menores en grave estado
El accidente fatal se registró alrededor de las 23.00 del domingo, sobre la ruta PY06, a la altura del km 152, Colonia Naranjito, distrito...
Posadeños expectantes ante posible reapertura de la frontera con Encarnación
Comerciantes asociados a la Cámara de Comercio e Industria de Posadas (CCIP) mantienen constantes reuniones con integrantes del sector y empiezan a prepararse ante...
Jóvenes de Caazapá reciben pago por becas universitarias
En el Salón Auditorio de la Cooperativa Ycuá Bolaños Caazapá, están convocados estudiantes de todos los distritos. A las 8:00, se inicia el pago...
«Trio amoroso» hurtó bienes de un motel
Ni los moteles se salvan. Este establecimiento fue visitado por un amoroso trío de delincuentes, quienes ingresaron en la madrugada a bordo de una...